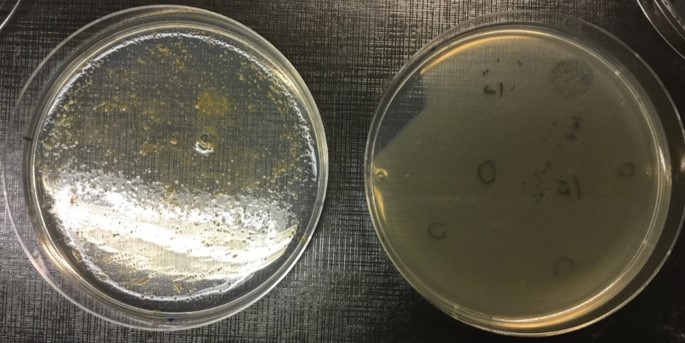
Figure1

Tripartite biological interactions between viruses, bacteria and animals
Published in Microbiology

It all started in March 2016, after literally moving to the other side of the World to start working with phages. Inspired by the Bacteriophage Adherence to Mucus (BAM) model [1], we decided to study how mucosal surfaces would affect the interaction of phages with Flavobacterium columnare (an important pathogen for aquaculture). After a successful pilot experiment showing that mucin had a positive effect for bacterial and phage growth, months of frustration came when the bacterium started to behave badly. F. columnare is not an easy host to use, and its ability to respond to small variations in the environment can make it grow in unexpected ways [2]. In our case, probably a shift in the water source used for media preparation made the bacteria stop to form confluent lawns on soft-agar plates, ruining most attempts to use it for phage titrations.
After testing many variables and starting side projects, finally a solution appeared. It turns out that F. columnare growth in semi-solid conditions can be greatly improved by the addition of mucin to the media (Figure 1). In fact, the mucin effect on the bacterium was so efficient for phage growth that we ended up developing methods concerning its use for phage production, titration and isolation. Finally we could continue what was started almost a year previously.
Using the large collection of phages and F. columnare strains from our laboratory we were able to show that mucin had a dual effect: on one side it increased bacterial virulence factors and virulence to cause disease in fish in vivo, while at the same time it made the bacteria more susceptible to be infected by phages (Figure 2). This is an important trade-off that the bacteria must face while trying to infect an animal. Besides, it fits well with the BAM model, especially considering that we also verified that our phages were capable of binding to mucin-coated agar plates.

By using live fish, we proved that phage retention in mucosal layers happens even in flow-through systems, from which phages can be retrieved from the fish mucus one week after a single phage dose (Figure 3). The retention of phages on mucus could be correlated to fish survival after exposure to F. columnare, showing that the symbiosis proposed by the BAM model is indeed relevant in our system.

In 2018 we started to test other phage-bacterium species to include as negative controls. To our surprise, two bacterium isolates unrelated to F. columnare from our collection behaved the same: by exposing Aeromonas sp. hosts to mucin or primary mucus we could see formation of biofilm on the cultures, and their phages grew better on the simulated mucosal cultures. This finding, together with evidences from the literature, allowed us to propose that the phenomena described could be widespread in nature. A manuscript was prepared, well received in its pre-print format, and now is published [3].
What can be learned from our work? First of all, that the interaction media matters and data in vitro might not translate well to data in vivo. Mucus plays a relevant role for mucosal pathogens in nature, and only in its presence we can really understand the ecological and clinical aspects of infection. Mucin exposure can be explored for biotechnology purposes, as in the case of producing high-titer phage stocks, and with it we were able to produce enough phages to be tested in a real aquaculture setting [4]. Mucus also helps in isolating new phages, and we hope that our data will inspire other groups to search (and find) F. columnare phages elsewhere. So far these phages were only described from Finland.
Another relevant point that can be taken from our data is how phage retention in mucosal layers may be used for disease prevention. In a time marked by the dawn of the post-antibiotic era and the revival of phage therapy in the Western World, exploring phage-mucus interactions for preventive protection is of extreme importance. There are a few modern publications showing the efficacy of preventive phage therapy, and the Soviet Union has used prophylactic phaging with success in the past [5-7]. However, so far there was no mechanism to support (and improve) preventive phage use, and that might explain why it is not commonly addressed.
Phage-bacteria-mucus interactions is a good starting point to justify phage prophylaxis. Cocktails of mucus-binding phages could be developed and used for modulating the microbiome of mucosal surfaces, creating transient protective layers against bacterial diseases. These could be useful for preventing diseases in healthcare workers, in travellers visiting regions with endemic bacterial diseases (and the local populations), in risk groups to certain conditions, in farmed animals, and many other uses. The impact for reducing mortality and morbidity related to bacterial infections can be huge. Using phages as microbiome modulators and not directly as medicine could also help in solving current issues regarding regulations for phage treatments.
There is still a long way until we can justify the use of preventive phage therapy. But so far it seems that the road to the revival of prophylactic phaging will be paved with mucus.
References
[1] Barr JJ, Auro R, Furlan M, et al. Bacteriophage adhering to mucus provide a non-host-derived immunity. Proc Natl Acad Sci. 2013;110(26):10771-10776. doi:10.1073/pnas.1305923110.
[2] Straus DL, Farmer BD, Beck BH, Bosworth BG, Torrans EL, Tucker CS. Water hardness influences Flavobacterium columnare pathogenesis in channel catfish. Aquaculture. 2015. doi:10.1016/j.aquaculture.2014.10.003
[3] Almeida GMF, Laanto E, Ashrafi R, Sundberg L-R. 2019. Bacteriophage adherence to mucus mediates preventive protection against pathogenic bacteria. mBio 10:e01984- 19. https://doi.org/10.1128/mBio.01984-19
[4] Almeida GMF, Mäkelä K, Laanto E, Pulkkinen J, Vielma J, Sundberg LR. The Fate of Bacteriophages in Recirculating Aquaculture Systems (RAS)—Towards Developing Phage Therapy for RAS. Antibiotics 2019, 8, 192. doi:10.3390/antibiotics8040192
[5] Yen M, Cairns LS, Camilli A. A cocktail of three virulent bacteriophages prevents Vibrio cholerae infection in animal models. Nat Commun. 2017;8. doi:10.1038/ncomms14187
[6] Ahmadi M, Amir Karimi Torshizi M, Rahimi S, Dennehy JJ. Prophylactic bacteriophage administration more effective than post-infection administration in reducing Salmonella enterica serovar enteritidis shedding in Quail. Front Microbiol. 2016;7(AUG). doi:10.3389/fmicb.2016.01253
[7] Chanishvili, N. (2009). A Literature Review of the Practical Application of Bacteriophage Research. New York, NY: Nova Science Publishers.


Please sign in or register for FREE
If you are a registered user on Research Communities by Springer Nature, please sign in